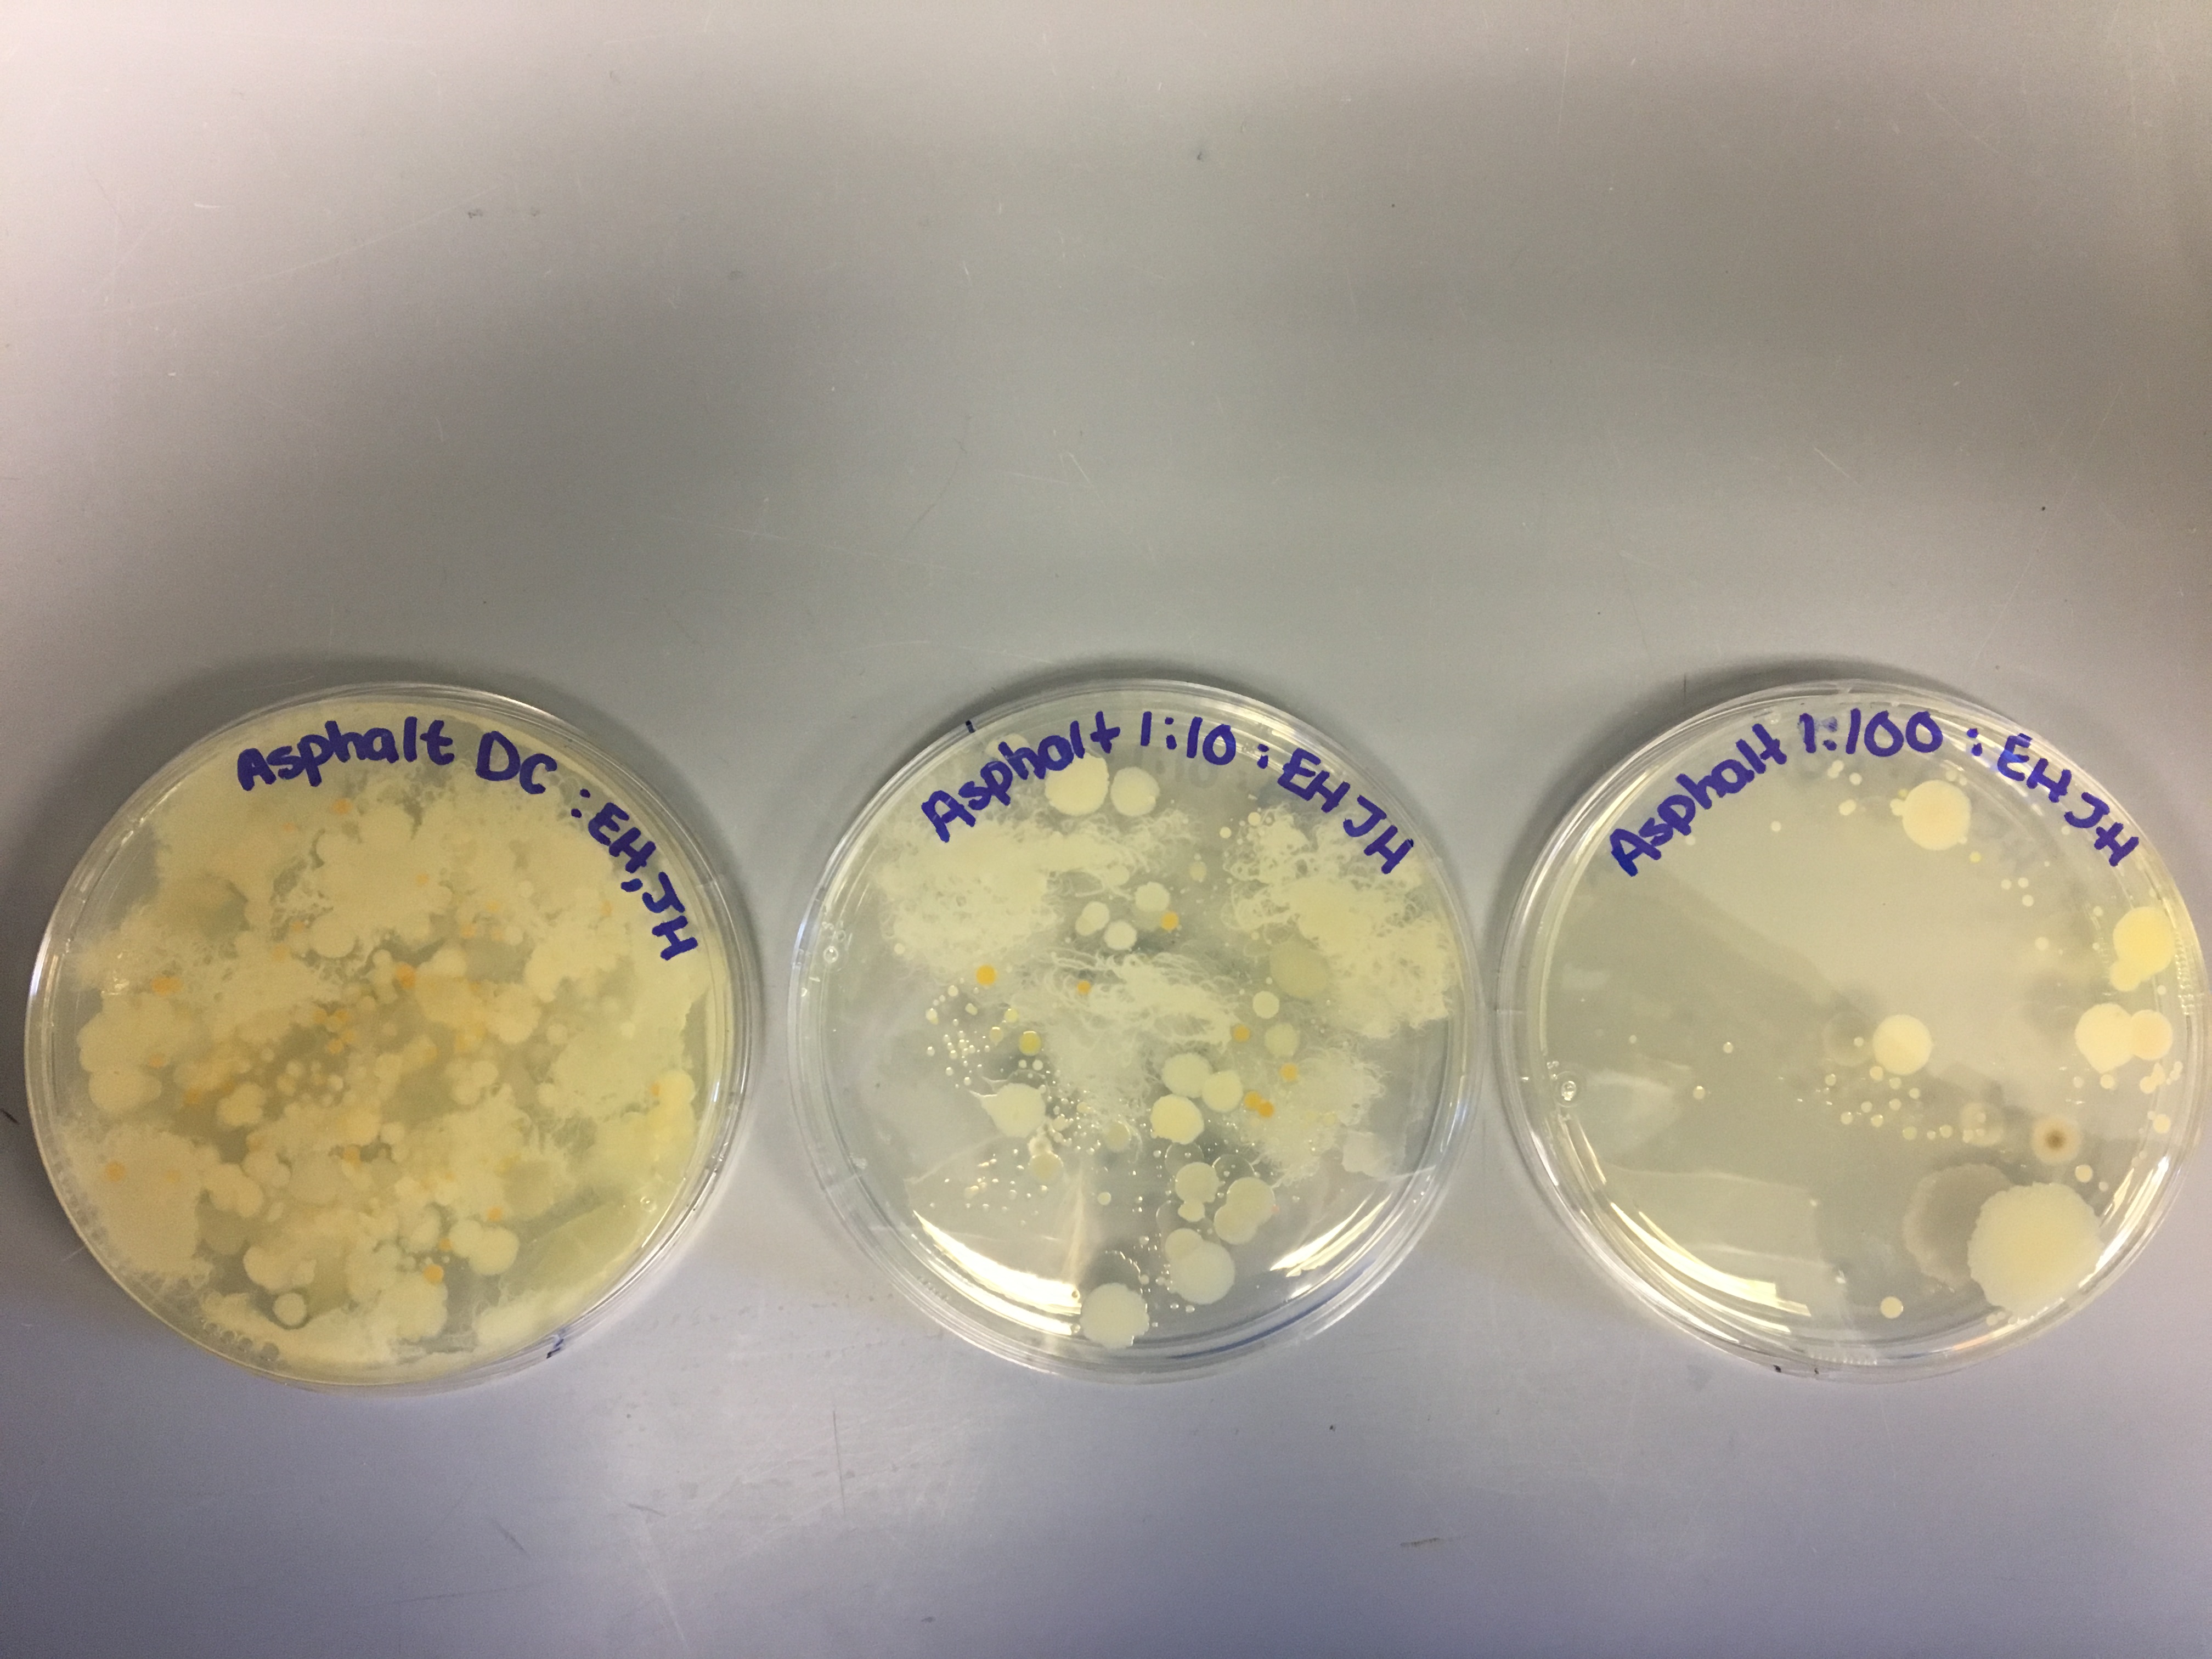

Featured
What Happens To Bacteria At 37 Degrees
What Happens To Bacteria At 37 Degrees. They are also adapted to concentrations of salt. Click to see full answer.
The exponential or log phase is a time of. Bacteria that require extreme cold temperatures 5 deg may not be optimal but they wouldn't be dormant. But, if you keep it longer at 37*c or room temperature, the bacteria may start dying (depends upon the type of bacteria), because the bacteria will replicate continuously in this condition, and.
Going To The Edge Of Their Adapted Range On The Cold Side, One Of The Major Things That Happens Is That.
The initial phase is the lag phase where bacteria are metabolically active but not dividing. The danger zone is the temperature at which bacteria grows and becomes dangerous. Bacteriawill die at temperaturesabove 212 degrees.
But, If You Keep It Longer At 37*C Or Room Temperature, The Bacteria May Start Dying (Depends Upon The Type Of Bacteria), Because The Bacteria Will Replicate Continuously In This Condition, And Those Dead Bacteria May Release Toxic Substance In The Culture Media And That Can Effect The Growth Of Other Live Bacteria.
Bacteria multiply rapidly between 40 and 140 degrees. Bacteria that require higher temperatures to survive may be dormant or close to it. Besides, why do we incubate bacteria at 25 degrees?
The Average Temperature For A Human Will Be The Same Temperature The Bacteria Are Likely To Flourish At Which Is About 37 Degrees Celsius Or 98 Degrees Fahrenheit.
Generally pathogenic microorganisms are incubated at 37 degrees , as 37 is normal body temperature of humans so the pathogens grow greatly at this temperature. Why are nutrient agar plates incubated at 37 degrees c and sabouraud agar at 25 degrees c. As amelia said, bacteria, like all organisms, are adapted to a temperature range.
For Example, Although Both Pathogens And.
Why are bacteria incubated at 37 degrees? The plates were then kept at room temperature for 0, 1, 3, 5, and 8 hours before overnight incubation at 37 degrees c (s. Bacteria that are mesophiles or needs optimal temperatures say like our body temperature 37 deg c, may show reduced activity.
The Exponential Or Log Phase Is A Time Of.
↑what happens to bacteria at degrees? Lag, exponential (log), stationary, and death. They are also adapted to concentrations of salt.
Popular Posts
How Long Was The Vietnam War And How Many Died
- Get link
- X
- Other Apps
Comments
Post a Comment